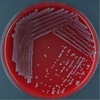

Test 2- Bordetella Flashcards
Bordetella General
• Gram-negative
- Small
- Cocco-bacillus
- Slower growth
- T optim. 30-37oC
- Obligate symbiotic
- Facultative pathogenic

Bordetella species
- B. bronchiseptica
- B. avium
- B. pertussis
- B. parapertussis
last two human whooping cough
B. Bronchiseptica General
- Facultative pathogen
- Aerobic
- In the upper respiratory tract of many animal species
• Affinity for ciliated respiratory epithelium
• Genetically closely related to B. pertussis/parapertussis
B. bronchiseptica Syndromes in different animal species
• Mainly pathology in:
• Dogs: kennel cough
• Pigs: atrophic rhinitis
- Rabbits
- Guinea pigs
Less in
- Cats
- Horses
Seldom
• Ruminants
Virulence factors
• Adhesins: ciliated respiratory epithelia
• Filamentous hemagglutinin
—— Secreted protein that remains attached to the OM
——–Most important adhesion factor
- —— Also causes hemagglutination
- ——- Also Adhesion to macrophages
- Pertactin (OMP)
- Fimbriae: role unclear
• Biofilms (persistence)
Virulence factors
• Toxins
TOXINS:
Hemolysin(adenylate cyclase toxin)
—RTX family of toxins (repeat in toxin)
——Inhibition of function of neutrophils
—–Pore forming
- *Dermonecrotic toxin**
- ——-Causes skin necrosis upon injection
- ——Damages nasal tissue
- —— Damages osteoblasts
- —– Differentiate from P. multocida DNT (also called PMT) (activates osteoclasts)
Osteotoxin
—– Toxic for osteoblasts
• Tracheal cytotoxin
——Destruction of ciliated respiratory epithelium
• LPS, Siderophore, lactoferrin and transferrin binding proteins
Virulence factors- genetic
• Bvg regulon-
- —–Phase variation
- ——Virulent non virulent phase
- —– Coordinates expression (or not) of virulence genes
Low temperature Mg sulphate Nicotinic acid
- Non progressive atrophic rhinitis
- Non progressive atrophic rhinitis
- Damage of nasal mucosae
- Production of mucus increases
- Dermonecrotic toxin
- Pneumonic bordetellosis
Symptoms:
- Pneumonic bordetellosis in PIGS
• Age < 1 week: primary infection
• Age > 1 week: secondary infection
- Symptoms
- Coughing and dyspnea in young animals
- In general no fever
- Morbidity: high
- Mortality: variable to high
• Lesions in lungs
• Pneumonia
- Frontal and mid lobus
- Go from red to brown/yellow-brown
- Chronic: dry aspect
- Purulent bronchiolitis and alveolitis
- Progressive atrophic rhinitis
Diseases in pigs
+ Pasteurella multocida
Also producer of DNT (PMT), but with activation of osteoclasts
P. multocida, DNT+ (also called PMT)
• Colonization of nose
- —-Only if (byB.bronchiseptica)
- —- -Mucus production is sufficient (by B. bronchiseptica) ——-Damage of epithelium (NH3) (by B. bronchiseptica)
- —– High infection pressure (by P. multocida)
- Multiplication of P. multocida
- DNT production of P. multocida to infect Osteoclasts
• Severity of lesions-atrophic rhinitis depends on
- Infection pressure
- Age of colonization with Bb and Pm
- Dust
- Ventilation
– farm management as a whole
pic- can tell that the nose is not symmetrical


Progressive atrophic rhinitis
Epidemiology of Progressive atrophic rhinitis
Epidemiology
• Bb colonizes easier than Pm
• Direct contact or aerosol (short distance)
- Sow to offspring
- older piglets to younger- have to be careful not to mix pigs
- Progressive atrophic rhinitis
Symptoms
Symptoms
• Sniffling
- Sneezing
- Progressive disease
- Tears
- Serious: + blood

Diseases in pigs 3. Progressive atrophic rhinitis
• Nose:
• Anatomical deviation
—– Skewed
——- Ribbing’s of skin
———shortening
• Growth of the animals is less good
Treatment and prevention of atrophic rhinitis
- Difficult!!!
- No optimal therapy
• Combination of
• Hygiene, management factors
——Compartmentation
——-Ventilation
——-Constant temperature
- Antibacterial (Pm has quite some acquired resistance)
- Vaccination Sows
——DNT of Pm must be included
——-Inactivated Bb
———-Heat labile toxin of Pm
• Vaccination of piglets: questionable result
Diagnosis (B. bronchispetica)
- Cultivation
- Sampling nose (tonsils)
- —- Clean nose before
- ——Deep(useflexibleswab)
——- In transport medium
- Slow growth
- Better at 30 than 37oC
- Blood agar plates
- Overgrowth problems
- (Serology)
- PCR
pic: Small grey colonies Hemolysis under colony
Treatment of B. bronchispetica
• Naturally little susceptible to
- —— Nitrofurantoin
- ——-Spectinomycin, streptomycin
——– Ceftiofur
——–Ampi, amoxy
• Acquired resistance to sulfonamides is quite frequent
B. bronchiseptica: kennel cough
- Dogs (cats)
- Rhinitis
- Laryngitis
- Tracheobronchitis
- Pneumonia and pleuritis
Canine infectious tracheobronchitis (Kennel Cough)
- Freq +
- CanineParainfluenzavirus
• Canine adenovirus 1, 2
- canine herpesvirus 1
- canine distemper
- Reovirus 1, 2, and 3
• Mycoplasmacynos
Do not have to memorize
B. bronchiseptica: kennel cough
Pathogenesis
• Infection
——Endogenic
——-Exogenic
• Adhesion to ciliated epithelium
- —Damage
- —NH3 production & toxins
—-Inflammation
————-Mucus
————–Attraction of neutrophils
————–Tracheobronchial clearance
————–Obstruction smaller bronchi and bronchioli
—- Susceptibility to secondary infections
————–Damage mucociliary apparatus
————–inhibition macrophages (Adenylate cyclase)
B. bronchiseptica: kennel cough
Symptoms and immunity
• Symptoms
- Onset
- in general 6-7 weeks old
• Early 3-4 weeks
- Dry cough
- Nose,eye
- General Symptoms
- T0
- Food intake
• Activity
• Immunity
—– Slow development of local antibodies
——Thus long excretion (14 weeks)
B. bronchiseptica: kennel cough Diagnosis
- Diagnosis • Isolation
- BAL
B. bronchiseptica: kennel cough Treatment
- Self limiting disease (mostly)- vaccination
- Rest
- Symptomatic: inhibition of cough (care because you want the cough to be able to eliminate the bacteria)
- Hygiene and disinfection
- Antibiotics tetracyclines, only when + general symptoms
- Little susceptible to cephalosporins
- Aerosolization (polymixin B, Kanamycin, gentamicin)
B. bronchiseptica: kennel cough
Prevention
- Vaccination (combination with viruses)
- Inactivated vaccine
—-Primo vaccination
———-2 injections
———–3 weeks in-between
————Yearly rappel
• Note: interference with maternal immunity till W 4-6
live vaccine- RARE
Age: 3 weeks
Nasal inoculation
No antibiotics!
Fast protection (72h)
Less interference with maternal immunity
Yearly rappel
B. Bronchiseptica in cats
• Kittens
Symptoms
• Nasal discharge
- Tears
- Photophobia
- Sneezing
- Non-productive cough
- Dyspnoea
- Swelling of lymph nodus • Anorexia
- Fever
- Mortality
- Older animals: less severe symptoms
- Treatment = dogs
B. Bronchiseptica in horses
- Seldom
- Similar to cats and dogs
- Treatment:
- Prevention of dust (for all respiratory diseases)
- Rest: 3 weeks for full recovery
- Prevention of inhalation of spores of fungi
——– Hay!
——————— Wetting: in bath with water (spray is not enough)
——————— Feeding on floor
——————— Replace eventually by alfalfa
• Prevent straw
Bordetella in poultry
- B. avium
- DD from these Alcaligenes faecalis and Avibacterium paragallinarum
- Turkeys: Coryza
- Rhinotracheitis
- Acute (W 1-6) or chronic
- Frequentlycomplicated(bacteria,viruses) • Environmental contamination
Bordetella in poultry
• Coryza in turkeys
- Coryza in turkeys
- Respiratory problems in turkeys: Important
• Acute (age 1-6 wks)/chronic
- Etiology: complex
- Bordetella avium(primaryagent)
- TRT virus (paramyxo,avianmetapneumovirus)
————- Includes also swollen head syndrome
————- E. coli
————- Ornithobacterium rhinotracheale
- ———— Mycoplasma gallisepticum
- ————Chlamydia psittaci

Bordetella in poultry
• Coryza in turkeys
Bordetella in poultry Epidemiology
Etiology: complex
E. coli
Pasteurella multocida
Mycoplasma gallisepticum
Mycoplasma synoviae
Mycoplasma meleagridis
Older animals: carriers
Transfer via floor bedding, drinking water
Bordetella in poultry
• Symptoms
• High morbidity, low mortality
- Growth
- Seromucous nose discharge
- Eye
- Sneezing
- Head shaking
- Further evolution:
- trachealrales
- Open beak respiration • Dirtonwings
Bordetella in poultry
• Treatment
- Treatment
- Hygiene!
- No mixing of ages
- Inactivated vaccine for mother animals
• (antibiotics, little effect)
Bordetella in Rabbit
• Nearly all rabbits are carriers
- Symptoms
- Nasal discharge
- Sneezing, snoring • Congestion
- Conjunctivitis
- Tears
- Eye localization: blindness • Ear infection
- Abscesses (dd. S. aureus)
Bordetella in Rabbit
+ P. multocida bronchopneumonia
- Not a significant economic risk
- Treatment depending on the stage
- Mostly not necessary
- Antibiotics: be careful